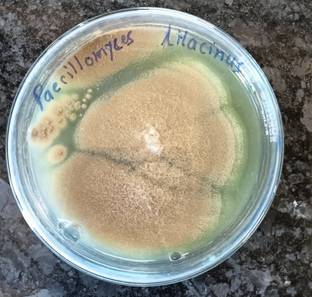
HEDO Nemato (Paecilomyces Lilacinus 2x10^8 CFU/g) Bio Organic for Seeds & Garden. Potting Mixture

Sale ends in19 hrs : 33 mins : 33 secs
KS TRADERS Jasmine Plant (Hybrid, Pack of 1)
Share
KS TRADERS Jasmine Plant (Hybrid, Pack of 1)
Be the first to Review this product
Special price
₹170
₹599
71% off
Available offers
T&C
T&C
T&C
T&C
Delivery
Check
Enter pincode
Delivery by25 Jan, Sunday
?
if ordered before 4:59 AM
View Details
Highlights
- Plant Name: Jasmine Plant
- Type: Flower
- Suitable Location: Indoor & Outdoor
- Container Type: Grow Bag
- Height: 90 mm
Services
- Cash on Delivery available?
Seller
Specifications
In The Box
| Pack of |
|
General
| Brand |
|
| Model Name |
|
| Type |
|
| Life Cycle |
|
| Plant Name |
|
| Suitable Location |
|
| Container Type |
|
| Container Material |
|
| Feng Shui Plant |
|
| Hybrid |
|
| Suitable For |
|
| Net Quantity |
|
| Plant Size |
|
| Container Color |
|
| Organic |
|
| Gift Pack |
|
Dimensions
| Height |
|
| Box Width |
|
| Box Height |
|
| Box Depth |
|
| Weight |
|
| Width |
|
| Container Height |
|
| Container Width |
|
Be the first to ask about this product
Safe and Secure Payments.Easy returns.100% Authentic products.
Back to top